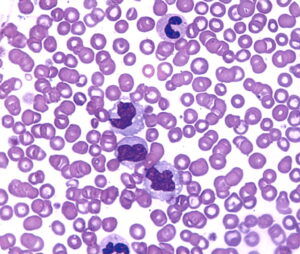
Understanding Neutrophil to Lymphocyte Ratio (Part 2): Research Demonstrating its Role as a Valuable Prognostic Marker in Cancer 2 F1.large

Understanding Neutrophil to Lymphocyte Ratio (Part 2): Research Demonstrating its Role as a Valuable Prognostic Marker in Cancer
A large body of research (as well as my clinical observations) point to chronic inflammation as a powerful force in the initiation, growth, and spread of cancer. As a result, an essential component of my protocol for health includes addressing inflammation.
As I discussed in part 1 of this series, there are three points to consider when evaluating the role of inflammation in cancer. First, a chronic inflammatory state can initiate cancer development. Second, it’s important to discover and address the root cause of the inflammation—for example, pathogenic (chronic infection), life-style, stress, and/or poor dietary habits. And third, recognize that the cancer itself creates inflammation—as the cancer energy mutates and gains intelligence, it manipulates the immune system, creating a pro-inflammatory micro-environment favorable to cancer growth.
Research indicates that the systemic manifestations of inflammation can provide a valuable biomarker for prognosis and treatment stratification. In particular, numerous studies indicate that a simple indicator of systemic inflammation—based on neutrophilia and/or lymphocytopenia—can provide prognostic information in a wide range of cancer types. In particular, the value of one index (the dNLR) derived from total white cell and neutrophil counts, is enabling large retrospective studies to be carried out.
Neutrophil to Lymphocyte Ratio May Be a Predictor of Mortality in All Conditions
White blood cell (WBC) count is one of the useful inflammatory biomarkers in clinical practice. For example, even if WBC is within normal range, subtypes of WBC including N/L ratio may predict cardiovascular mortality.
N/L ratio is a readily measurable laboratory marker used to evaluate systemic inflammation. There are many different conditions that can affect N/L ratio, including hypertension, diabetes mellitus, metabolic syndrome (1), left ventricular dysfunction, acute coronary syndromes, valvular heart disease, abnormal thyroid function tests, renal or hepatic dysfunction, known malignancy (2,3,4), local or systemic infection, previous history of infection (<3 months), inflammatory diseases, and any medication related to inflammatory conditions.
Here’s one example of how the N/L ratio can be useful as part of the evaluation of a specific cancer and the treatment protocol: not only N/L ratio but also mean platelet volume, red cell distribution width (5), platelet distribution width, CRP, uric acid and gamma-glutamyl transferase (6) are easy markers to evaluate the prognosis of colon cancer patients (7). However, one should keep in mind that N/L ratio itself alone without other inflammatory markers may not give exact information to clinicians about the prognosis of colon cancer patients. (8,9).
Neutrophils: Key Mediators of Tumor Angiogenesis
It is well known that most malignant tumors contain a significant amount of leucocytic infiltrates, which are linked to poor patient prognosis. These leucocyte populations are recruited to tumors by chemotactic factors released by either viable or necrotic tumor cells, or by cells within the tumor stroma.
Most studies have analyzed the role that tumor-associated macrophages (TAM) have on tumor progression. However, there is now increasing evidence that neutrophils also actively participate in this process. Research indicates that neutrophil-derived factors can promote genetic mutations leading to tumourigenesis and secrete factors that promote tumor cell proliferation. There is now also substantial evidence to show that neutrophils, like TAM, significantly affect tumor angiogenesis.
There are several mechanisms by which neutrophils recruit various cells into the tumor and induce tumor vascularization by the secretion of powerful pro-angiogenic factors. An important anti-tumor target for combating tumor-associated angiogenesis should include inhibiting neutrophil recruitment (10).
The following are some of the most compelling studies on the relationship of cancer and inflammation to date:
- High neutrophil to lymphocyte ratio in pancreatic cancer predicts shorter overall survival.
Both neutrophils and lymphocytes are known markers of inflammation, a predictor of worse outcome regardless of tumor type, according to David Goldstein MD, University of New South Wales, Sydney, Australia, and colleagues.
In a study of 861 patients with metastatic pancreatic cancer, researchers identified NAL, a marker of systemic inflammation, as a very important negative prognostic factor, said Dr. Goldstein. When the NAL ratio was ≤5, overall survival was 9.1 months; when the NAL ratio was >5, overall survival was 5.0 months. (11)
- Neutrophil-lymphocyte ratio predicts overall and recurrence-free survival after liver transplantation for hepatocellular carcinoma.
In a retrospective analysis of 160 adult patients undergoing liver transplantation for hepatocellular carcinoma (HCC), researchers found that elevated neutrophil-lymphocyte ratio (NLR) at the time of diagnosis predicted survival of patients with (HCC) after liver transplantation (LT). They defined an elevated NLR as a ratio of 5 or greater.
The researchers found that preoperative NLR is a powerful independent predictor of overall survival and recurrence-free survival in patients undergoing LT for HCC. They suggest that measurement of NLR could serve as a useful and easily obtained adjunct to the Model for End-Stage Liver Disease score and Milan criteria when evaluating this patient population and determining which patients will gain the most survival benefit from transplantation (12).
- Markers of systemic inflammation predict survival in patients with advanced renal cell cancer.
Researchers examined the prognostic value of inflammatory markers (albumin, white-cell count and its components, and platelets) in 362 pre-treated patients with advanced renal cell carcinoma (RCC). They found elevated neutrophil counts, elevated platelet counts, and a high neutrophil–lymphocyte ratio were significant independent predictors for shorter overall survival (OS), concluding that markers of systemic inflammation contribute significantly to prognostic classification in addition to established factors for pre-treated patients with advanced RCC (13).
- A derived neutrophil to lymphocyte ratio predicts clinical outcome in stage II and III colon cancer patients.
Researchers analyzed the dNLR with clinical outcome in stage II and III colon cancer patients. This retrospective study included 372 patients with stage II and III colon cancer.
In univariate analysis, the elevated preoperative dNLR was significantly associated with decreased time to relapse (TTR) and remained significant in multivariate analysis. Patients with dNLR >3 had a median TTR of 83 months, and patients with dNLR 3 showed a median TTR of 132 months. In OS analysis, a dNLR >2.2 was significantly associated with decreased OS in univariate and multivariate analysis. Patients with dNLR >2.2 showed a median OS of 121 months, and patients with dNLR 2.2 had a median OS of 147 months. The researchers concluded that dNLR may be an independent prognostic marker for TTR and OS in patients with stage II and III colon cancer. (14).
- Elevated blood neutrophil-to-lymphocyte ratio is associated with poor survival in high-risk melanoma.
An increased preoperative peripheral blood neutrophil-to-lymphocyte ratio (NLR) is independently associated with decreased overall survival (OS) in patients with high-risk melanoma (stage IIB to III), according to study results presented at the 68th Annual Meeting of the Society of Surgical Oncology (SSO).
The research team identified 835 patients with high-risk, non-metastatic melanoma. The median NLR was 2.73. Patients with ratios above and below this value were classed as high NLR and low NLR, respectively.
Patients with median NLR did not have appreciable differences in tumor location, ulceration, clinical node status, pathologic nodal status, or pathologic stage of melanoma. High NLR was strongly associated with poorer OS, with the median OS for patients with high NLR being 58.8 months and the median OS for patients with low NLR 103.2 months.
The accumulation of inflammatory cells around neoplasms appears to be significant in the development of tumors and in patient prognosis, the researchers noted. A high density of lymphocytes in the tumor stroma (i.e., lower NLR) has been associated a better clinical outcome; the presence of more neutrophils (i.e., higher NLR) has been linked with poor clinical outcome. The shifting content of circulating white blood cells, including neutrophils and lymphocytes, in the vicinity of a tumor can reflect the systemic inflammatory response.
Absolute numbers of these cells can fluctuate to different degrees on a daily basis, however. Determining the NLR, which represents the relative value of neutrophil and lymphocyte counts, more accurately reflects fluctuations between neutrophils and lymphocytes, and can better gauge the anti-tumor efficacy of the host immune system. The researchers expressed hope that the parameter could be developed therapeutically, with elevated NLR triggering a more intensive therapeutic course (15).
- High blood neutrophil-to-lymphocyte ratio is an indicator of poor prognosis in malignant mesothelioma patients undergoing systemic therapy.

In this retrospective evaluation, researchers studied 173 patients with malignant mesothelioma (MM) undergoing systemic therapy, including 119 patients receiving first-line therapy and 54 patients receiving second- or third-line therapy. Forty-two percent of patients had an elevated NLR at baseline. After multivariate analysis, histologic epithelioid subtype [hazard ratio (HR) = 2.0; 95% confidence interval (CI) = 1.3-2.9; P = 0.001], and NLR less than 5 (HR = 2.7; 95% CI = 1.8-3.9; P < 0.001) remained independent predictors. The 1-year survival rate was 60% versus 26%, whereas the 2-year survival rate was 34% versus 10% for NLR less than 5 and 5 or greater, respectively.
In the separate analyses of chemotherapy-naive and previously treated patient groups, NLR was an independent predictor of survival in both groups. The researchers concluded that NLR is an independent predictor of survival for patients with MM undergoing systemic therapy. (16)
- The prognostic significance of preoperative leukocytosis and neutrophil-to-lymphocyte ratio in patients who underwent radical cystectomy for bladder cancer.
In this study, researchers retrospectively reviewed the medical records of 286 patients who underwent radical cystectomy for bladder cancer. Age, gender, pathologic stage, lymph node involvement, preoperative hydronephrosis, histologic sub-type, surgical margin status, and lymphovascular invasion were recorded for each patient. Univariate and multivariate analysis were performed to determine the prognostic value of the preoperative clinical and laboratory parameters on disease-specific survival (DSS). Additionally, the correlation between leukocytosis and other factors were evaluated.
According to the univariate analysis preoperative leukocytosis and NLR were detected as negative prognostic factors on DSS. Preoperative leukocytosis, NLR, stage, lymph node involvement, histologic subtype, grade and age were independent prognostic factors for DSS, on multivariate analysis. Patients with leukocytosis had higher stage, grade and lymphovascular invasion.
The researchers concluded that inexpensive, reproducible, and readily available peripheral blood count components of white blood cell count and NLR were independent prognostic factors, which can stratify DSS risks in bladder cancer patients who underwent radical cystectomy (17).
- Neutrophil to lymphocyte ratio (NLR) improves the risk assessment of ISS staging in newly diagnosed MM patients treated upfront with novel agents.
Researchers retrospectively examined the NLR in a cohort of 309 newly diagnosed multiple myeloma (MM) patients treated upfront with novel agents. NLR was calculated using data obtained from the complete blood count (CBC) at diagnosis and subsequently correlated with PFS and OS. The median NLR was 1.9 (range 0.4-15.9). Higher NLR was independent of international staging system (ISS) stage, plasma cell infiltration or cytogenetics. The 5-year PFS and OS estimates were, respectively, 18.2 and 36.4 % for patients with NLR ≥ 2 versus 25.5 and 66.6 % in patients with NLR < 2.
Among younger patients (age <65 years, N = 179), NLR ≥ 2 had a negative prognostic impact on both PFS and OS, in all ISS stages. By combining ISS stage and NLR in a model limited to young patients, researchers found that 19 % of the patients were classified as very low risk, 70 % standard risk and 11 % very high risk. The 5-year estimates were 39.3, 19.4 and 10.9 % for PFS and 95.8, 50.9 and 23.6 % for OS for very low, standard-risk and very high-risk groups.
The researchers concluded that NLR is a predictor of PFS and OS in MM patients treated upfront with novel agents. NLR can be combined with ISS staging system to identify patients with dismal outcome. However, larger cohorts and prospective studies are needed to use NLR as additional parameter to personalize MM therapy in the era of novel agents (18).
• Derived neutrophil lymphocyte ratio is predictive of survival from intermittent therapy in advanced colorectal cancer: a post hoc analysis of the MRC COIN study.

The phase III Continuous or Intermittent (COIN) trial failed to show non-inferiority of intermittent compared with continuous chemotherapy for advanced colorectal cancer in overall survival (OS). The present analysis evaluated whether the derived neutrophil to lymphocyte ratio (dNLR) could predict the effect of intermittent vs continuous chemotherapy on OS in patients with advanced colorectal cancer.
A post hoc exploratory analysis of COIN arms A and C was performed. Landmark analysis was conducted on all patients with available WBC and neutrophils data. The dNLR was calculated using a formula which has previously demonstrated predictive power in cancer patients: dNLR=ANC/(WBC−ANC). A high dNLR was
defined using a cut-off value of 2.22. Derived neutrophil to lymphocyte ratio was then correlated with clinical outcomes. Survival curves were generated based on dNLR using the Kaplan–Meier method. Comparison between groups was performed using Cox regression.
A total of 1630 patients were assigned to the continuous (N=815) or intermittent (N=815) arms. Researchers found a strong association between dNLR level and OS. The median survival times in the ITT population were 18.6 months and 12.5 months for patients with low and high dNLR, respectively (HR=1.70; 95% CI=1.52–1.90; P<0.001). The estimate of the hazard ratio did not alter substantially (HR=1.54) after adjusting for treatment, tumor status, number of metastatic sites, alkaline phosphate and platelet count.
The researchers concluded that derived neutrophil to lymphocyte ratio is strongly prognostic for survival in the COIN intermittent vs continuous treatment arms (19).
- Neutrophil/lymphocyte ratio has a prognostic value for patients with terminal cancer
Determining prognosis in advanced cancer is of key importance. Various prognostic scores have been developed. However, they are often very complex. In this study, we evaluated the feasibility of neutrophil/lymphocyte ratio (NLR) as an index to estimate survival in terminal cancer patients.
The researchers calculated NLR retrospectively based on blood tests performed at 3 months, 2 months, 4 weeks, 3 weeks, 2 weeks, 1 week, and within 3 days before death in 160 cancer patients (82 men, 78 women; age range, 33-99 years; mean age, 69.8 years).
Mean NLR was significantly higher in patients who died within 4 weeks (29.82) than in those who lived more than 4 weeks (6.15). The NLR cutoff point was set at 9.21 according to receiver operating characteristic curve analysis (area under the curve, 0.82; 95 % confidence interval, 0.79-0.85). We inferred that life expectancy would be<4 weeks when NLR>9.21.
The researchers concluded that NLR appears to be a useful and simple parameter to predict the clinical outcomes of patients with terminal cancer (20).
References:
- Balta S, Cakar M, Demirkol S, Arslan Z, Akhan M (2013a) Higher neutrophil to lymhocyte ratio in patients with metabolic syndrome. Clin Appl Thromb Hemost 19(5): 579.
- Stotz M, Gerger A, Eisner F, Szkandera J, Loibner H, L Ress A, Kornprat P, A Zoughbi W, Seggewies FS, Lackner C, Stojakovic T, Samonigg H, Hoefler G, Pichler M (2013) Increased neutrophil-lymphocyte ratio is a poor prognostic factor in patients with primary operable and inoperable pancreatic cancer. Br J Cancer 109: 416–421.
- Szkandera J, Absenger G, Liegl-Atzwanger B, Pichler M, Stotz M, Samonigg H, Glehr M, Zacherl M, Stojakovic T, Gerger A, Leithner A (2013) Elevated preoperative neutrophil/lymphocyte ratio is associated with poor prognosis in soft-tissue sarcoma patients. Br J Cancer 108: 1677–1683.
- Demirkol S, Balta S, Celik T, Arslan Z, Unlu M, Cakar M, Kucuk U, Demirbas S, Iyisoy A, Yokusoglu M (2013) Assessment of the relationship between red cell distribution width and cardiac syndrome X. Kardiol Pol. 71: 480–484.
- Demirkol S, Balta S, Unlu M, Yuksel UC, Celik T, Arslan Z, Kucuk U, Yokusoglu M (2012) Evaluation of the mean platelet volume in patients with cardiac syndrome X. Clinics (São Paulo, Brazil) 67: 1019–1022.
- Cakar M, Balta S, Demirkol S, Altun B, Demirbas S (2012) Serum gamma-glutamyltransferase (GGT) should be evaluated together with other ınflammatory markers in clinical practice. Angiology 124: 60
- Cakar M, Sarlak H, Balta S, Unlu M, Demirbas S, Demirkol S (2013) Serum uric Acid still carries controversies about its role in endothelial dysfunction. J Clin Hypertens (Greenwich) 15: 296.
- Balta S, Demirkol S, Cakar M, Arslan Z, Unlu M, Celik T (2013b) Other Inflammatory Markers should not be forgotten when assessing the neutrophil-to-lymphocyte ratio. Clin Appl Thromb Hemost e-pub ahead of print 23 April 2013 doi:10.1177/1076029613486019.
- Balta S, Demirkol S, Celik T, Kucuk U, Unlu M, Arslan Z, Balta I, Iyisoy A, Kocak N, Haqmal H, Yokusoglu M (2013c) Association between coronary artery ectasia and neutrophil-lymphocyte ratio. Angiology e-pub ahead of print 17 March 2013 doi:10.1177/0003319713480424.
- Simon Tazzyman, Claire E Lewis, Craig Murdoch, Neutrophils: key mediators of tumour angiogenesis Int J Exp Pathol. 2009 June; 90(3): 222–231. doi: 10.1111/j.1365-2613.2009.00641.x
- Alexander, W., High Neutrophil to Lymphocyte Ratio in Pancreatic Cancer Predicts Shorter Overall Survival, June 6, 2014, presented here at the 2014 Annual Meeting of the American Society of Clinical Oncology (ASCO); Presentation title: Analyses of Updated Overall Survival (OS) and Prognostic Effect of Neutrophil-to-Lymphocyte Ratio (NLR) and CA 19-9 From the Phase III MPACT Study of Nab-Paclitaxel (Nab-P) Plus Gemcitabine (Gem) versus Gem for Patients (Pts) With Metastatic Pancreatic Cancer (PC). Abstract 4027]
- Limaye AR1, Clark V, Soldevila-Pico C, Morelli G, Suman A, Firpi R, Nelson DR, Cabrera R. Neutrophil-lymphocyte ratio predicts overall and recurrence-free survival after liver transplantation for hepatocellular carcinoma, Hepatol Res. 2013 Jul;43(7):757-64. doi: 10.1111/hepr.12019. Epub 2012 Nov 30.
- P Fox, M Hudson, C Brown, S Lord, V Gebski, P De Souza and C K Lee. Markers of systemic inflammation predict survival in patients with advanced renal cell cancer, British Journal of Cancer 109: 147-153; Published online, 18 June 2013; doi:10.1038/bjc.2013.300
- G Absenger, J Szkandera, M Pichler, M Stotz, F Arminger, M Weissmueller, R Schaberl-Moser, H Samonigg, T Stojakovic and A Gerger, A derived neutrophil to lymphocyte ratio predicts clinical outcome in stage II and III colon cancer patients, British Journal of Cancer 109: 395-400; Published online, 02 July 2013; doi:10.1038/bjc.2013.346
- Davis, JL., Elevated Blood Neutrophil-to-Lymphocyte Ratio is associated with Poor Survival in Melanoma. Abstract 55; March 31, 2015, Memorial Sloan Kettering Cancer Center.
- Kao, S.C. et al. High blood neutrophil-to-lymphocyte ratio is an indicator of poor prognosis in malignant mesothelioma patients undergoing systemic therapy. Clin. Cancer Res. 16, 5805–5813 (2010).
- Ozcan C, Telli O, Ozturk E, Suer E, Gokce MI, Gulpinar O, Oztuna D, Baltaci S, Gogus C. The prognostic significance of preoperative leukocytosis and neutrophil-to-lymphocyte ratio in patients who underwent radical cystectomy for bladder cancer. Can Urol Assoc J. 2015 Nov-Dec;9(11-12):E789-E794. Epub 2015 Nov 4.
- Romano A, Parrinello NL, Consoli ML, Marchionni L, Forte S, Conticello C, Pompa A, Corso A, Milone G, Di Raimondo F, Borrello I. Neutrophil to lymphocyte ratio (NLR) improves the risk assessment of ISS staging in newly diagnosed MM patients treated upfront with novel agents. Ann Hematol. 2015 Nov;94(11):1875-83. doi: 10.1007/s00277-015-2462-4. Epub 2015 Jul 31.
- Tal Grenader, Stephen Nash, Richard Adams, Richard Kaplan, David Fisher, Tim Maughan and John Bridgewater, Derived neutrophil lymphocyte ratio is predictive of survival from intermittent therapy in advanced colorectal cancer: a post hoc analysis of the MRC COIN study, Br J Cancer 2016 114: 612-615; advance online publication, February 18, 2016; 10.1038/bjc.2016.23
- Nakamura Y, Watanabe R, Katagiri M, Saida Y, Katada N, Watanabe M, Okamoto Y, Asai K, Enomoto T, Kiribayashi T, Kusachi S; Neutrophil/lymphocyte ratio has a prognostic value for patients with terminal cancer; World Journal of Surgical Oncology 14 (1), 148 (2016).



